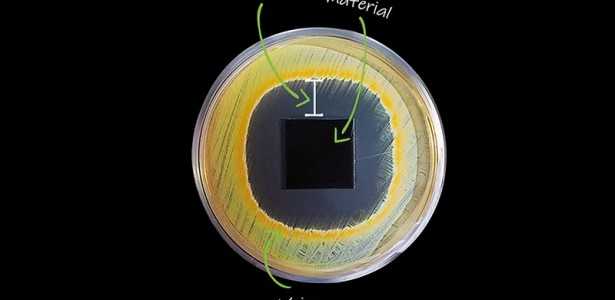
Empresa Spin-off do CDMF Ganha Prêmio no BRICS Solutions Awards 2025

Nanox Tecnologia é Reconhecida no BRICS Solutions Awards 2025
A Nanox Tecnologia, uma spin-off do Centro de Desenvolvimento de Materiais Funcionais (CDMF), recebeu o prestigioso prêmio BRICS Solutions Awards 2025 na categoria Segurança Alimentar e Produção Sustentável. O projeto premiado, intitulado Reduction of Food Loss and Waste, destaca a inovação e a sustentabilidade na luta contra o desperdício de alimentos.
O CDMF, um Centro de Pesquisa, Inovação e Difusão (CEPID) da FAPESP sediado na Universidade Federal de São Carlos (UFSCar), tem sido fundamental na promoção de tecnologias que enfrentam desafios estruturais, como a insegurança alimentar.
Destaques do Prêmio e Impacto Social
O prêmio foi concedido durante o BRICS Business Forum, realizado no Rio de Janeiro em agosto. Esse evento reuniu líderes de governos e empresas para discutir cooperação, inovação e desenvolvimento sustentável. A Nanox destacou-se entre os três melhores projetos voltados ao combate ao desperdício de alimentos, utilizando tecnologia nacional que incorpora nanopartículas com ação contra vírus, bactérias e fungos em peças de metal.
Importância da Iniciativa
O BRICS Solutions Awards 2025 reconhece iniciativas com impacto social e ambiental significativo nos países membros do bloco — Brasil, Rússia, Índia, China, África do Sul, Irã, Arábia Saudita, Egito, Etiópia e Emirados Árabes Unidos. A conquista da Nanox não apenas ressalta a eficácia das soluções tecnológicas brasileiras, mas também enfatiza a importância da redução de perdas alimentares para garantir a segurança alimentar e preservar recursos naturais.
Gustavo Pagotto, CEO da Nanox, afirma: "A conquista da Nanox reafirma o potencial das soluções brasileiras de base tecnológica para enfrentar problemas estruturais e promover a sustentabilidade em escala global."
Expansão Global da Nanox
Desde sua fundação em 2004, a Nanox tem se dedicado à nanotecnologia para fornecer soluções sustentáveis a empresas em todo o mundo. A empresa se expandiu para mercado na América do Norte, Europa e América Latina, mostrando seu compromisso em auxiliar a cadeia produtiva global a se tornar mais eficiente e sustentável.
Com esta premiação, a Nanox Tecnologia se estabelece como um líder em inovação e sustentabilidade, inspirando outras empresas a adotar práticas que não apenas combatem o desperdício, mas também promovem um futuro mais sustentável.
Informações da Agência FAPESP